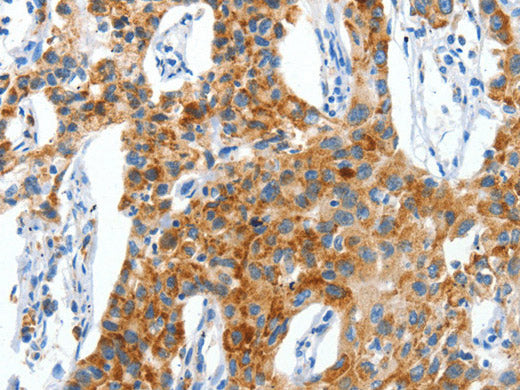
CKAP4 Polyclonal Antibody Store at -20°C

CKAP4 Polyclonal Antibody Store at -20°C
Couldn't load pickup availability

Still have questions? Ask our experts!
CKAP4 Polyclonal Antibody Store at -20°C
| SKU # | E-AB-13152 |
| Reactivity | Human, Mouse |
| Host | Rabbit |
| Applications | WB, IHC |
Product Details
| Isotype | IgG |
| Host | Rabbit |
| Reactivity | Human, Mouse |
| Applications | WB, IHC |
| Clonality | Polyclonal |
| Immunogen | Synthetic peptide of human CKAP4 |
| Abbre | CKAP4 |
| Synonyms | 63 kDa membrane protein, CKAP 4, CKAP4, Ckap4, Cytoskeleton associated protein 4, Cytoskeleton-associated protein 4, ERGIC 63, ERGIC63, MGC99554, Transmembrane protein 63kD endoplasmic reticulum Golgi intermediate compartment, Type II transmembrane protein p63, p63 |
| Swissprot | |
| Calculated MW | 66 kDa |
| Cellular Localization | Endoplasmic reticulum-Golgi intermediate compartment membrane. |
| Concentration | 0.6 mg/mL |
| Buffer | Phosphate buffered solution, pH 7.4, containing 0.05% stabilizer and 50% glycerol. |
| Purification Method | Affinity purification |
| Research Areas | Cancer |
| Conjugation | Unconjugated |
| Storage | Store at -20°C Valid for 12 months. Avoid freeze / thaw cycles. |
| Shipping | The product is shipped with ice pack, upon receipt, store it immediately at the temperature recommended. |
Related Reagents
| Applications | Recommended Dilution |
| WB | 1:1000-1:5000 |
| IHC | 1:50-1:200 |
Background
CKAP4 (cytoskeleton-associated protein 4), also known as p63, CLIMP-63 or ERGIC-63, is a 602 amino acid single-pass type II transmembrane protein that links the endoplasmic reticulum (ER) to the cytoskeleton. Considered a novel protein in maintaining ER morphology, CKAP4 anchors the ER to microtubles which is required for maintaining ER spatial distribution during interphase of the cell cycle.CKAP4 can be reversibly palmitoylated and phosphorylated and is a major substrate of the palmitoyl acyltransferase, ZDHHC2.